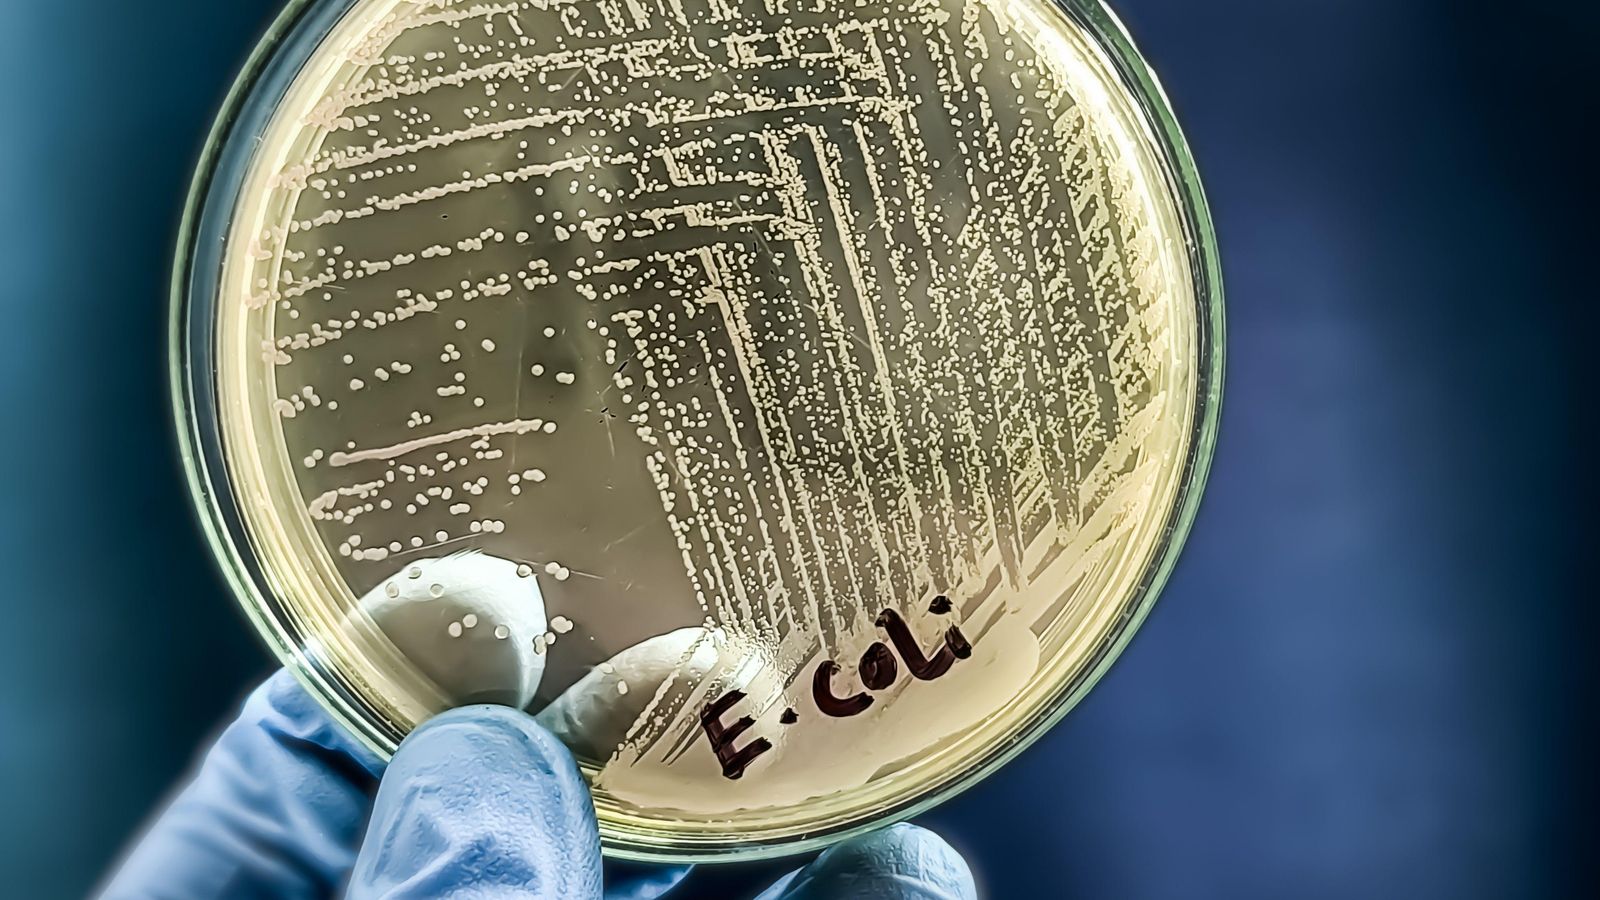
Culiu de la bactèria 'Escherichia coli'

El sedentarisme i l'insomni fan que els pacients de càncer siguen més vulnerables a l'ansietat i la depressió
Segons l'estudi de la UPV, saber quins pacients són més vulnerables possibilita tractaments preventius i optimitza les decisions clíniques
Un estudi de la UPV desvela quins pacients de càncer d'edat avançada tenen més risc de patir ansietat o depressió. Saber quins són els més vulnerables possibilita tractaments preventius i optimitzar les decisions clíniques del personal mèdic.
La falta d'exercici i el son irregular són factors que afecten molt la recuperació dels pacients de càncer en edat avançada. El sedentarisme i l'insomni fan que els pacients siguen més vulnerables a l'ansietat i la depressió, segons un estudi de l'institut Ítaca de la UPV.
D'altra banda, l'estudi també revela que les persones que pateixen càncer de pròstata amb metàstasi presenten més risc d'ansietat i depressió en comparació amb altres tipus de càncer de pell o mama.
L'estudi pertany al projecte europeu Horitzó 20/20. Hi han participat 121 pacients oncològics de Grècia, Suècia, Espanya i el Regne Unit. Les dades s'han recopilat amb dispositius com polseres intel·ligents amb ajuda d'intel·ligència artificial.